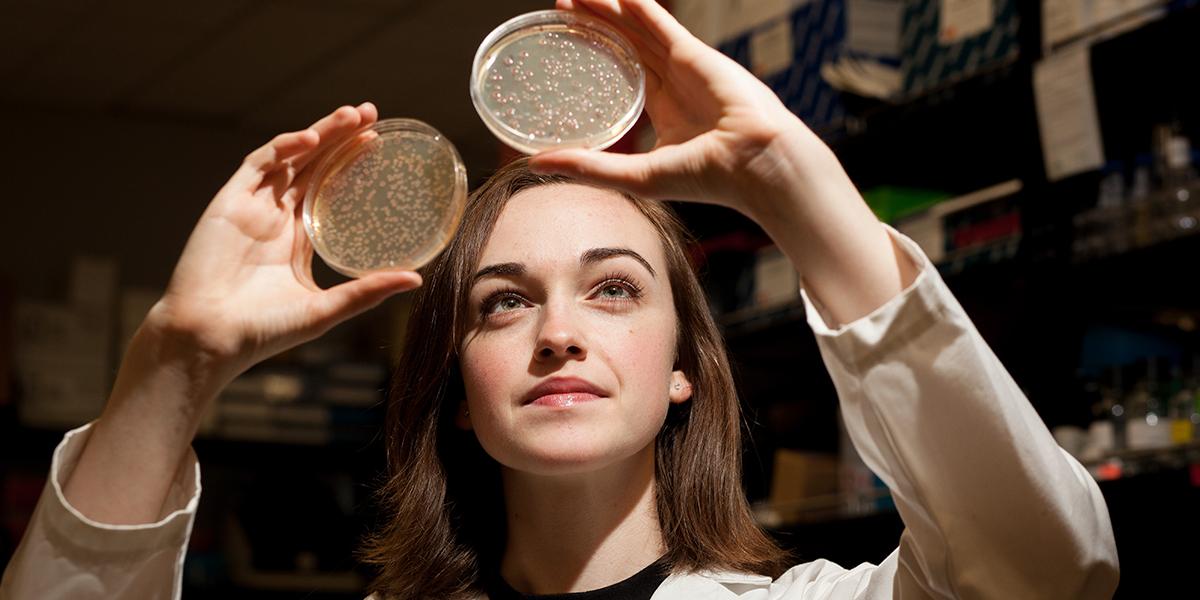
Meghan Perez

WKU Sisterhood Research Internship Grant
Made possible by a gift from the WKU Sisterhood in the fall of 2016, the WKU Sisterhood Research Internship Grant program offers internships for young women between their junior and senior years from the following underrepresented backgrounds:
- Young women who come from a Kentucky county in the Appalachian Region
- Young women with minority status as an African American/Black; Hispanic/Latino; American
Indian/Alaskan Native;
Two or more races - Young women who are first-generation college students
- Young women with a registered disability
- Young women who identify as LGBTQIA+
These internships will support summer research at WKU, across the Commonwealth, the USA, and the world.
The WKU Sisterhood is a group of women with shared values, who enjoy collaborating to advance the mission of WKU. Members pool their financial gifts and award funds to a limited number of university designations to maximize the impact of their philanthropy. Through their generous gift, the WKU Sisterhood has directly created research internships that otherwise would not have existed for this subset of young women. Recipients will use their internships as a springboard to later apply for prestigious awards such as the Siemens Competition, the Regeneron Science Talent Search, and the Goldwater Scholarship. Many recipients also submit their work for peer-reviewed publication and for conference presentations.
The 2021 Summer WKU Sisterhood Research Internship Grant Application
Deadline for submission will be Friday, March 19.
Gatton Research Internship Grant Forms
2021 Student Evaluation Form and Grading Parameters
Regeneron Rules, Forms, and Resources
Regeneron Research Report Requirements
Regeneron Institutional Review Board (IRB) Approval Form
WKU Sisterhood Research Internship Grant Past Placements
Some of the links on this page may require additional software to view.